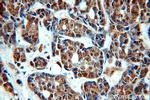
TOP2B Antibody in Immunohistochemistry (Paraffin) (IHC (P))

Search
Proteintech
TOP2B Polyclonal Antibody
{{$productOrderCtrl.translations['antibody.pdp.commerceCard.promotion.promotions']}}
{{$productOrderCtrl.translations['antibody.pdp.commerceCard.promotion.viewpromo']}}
{{$productOrderCtrl.translations['antibody.pdp.commerceCard.promotion.promocode']}}: {{promo.promoCode}} {{promo.promoTitle}} {{promo.promoDescription}}. {{$productOrderCtrl.translations['antibody.pdp.commerceCard.promotion.learnmore']}}
产品信息
20549-1-AP
种属反应
已发表种属
宿主/亚型
分类
类型
抗原
偶联物
形式
浓度
规格
纯化类型
保存液
内含物
保存条件
运输条件
产品详细信息
The antibody is specific to TOP2B.
靶标信息
TOP2B (DNA Topoisomerase II Beta) is a Protein Coding gene. This gene encodes a DNA topoisomerase, an enzyme that controls and alters the topologic states of DNA during transcription. This nuclear enzyme is involved in processes such as chromosome condensation, chromatid separation, and the relief of torsional stress that occurs during DNA transcription and replication. It catalyzes the transient breaking and rejoining of two strands of duplex DNA which allows the strands to pass through one another, thus altering the topology of DNA. Two forms of this enzyme exist as likely products of a gene duplication event. The gene encoding this form, beta, is localized to chromosome 3 and the alpha form is localized to chromosome 17. The gene encoding this enzyme functions as the target for several anticancer agents and a variety of mutations in this gene have been associated with the development of drug resistance. Reduced activity of this enzyme may also play a role in ataxia-telangiectasia. Alternative splicing results in multiple transcript variants.
仅用于科研。不用于诊断过程。未经明确授权不得转售。
生物信息学
蛋白别名: antigen MLAA-44; DNA topoisomerase 2-beta; DNA topoisomerase II, 180 kD; DNA topoisomerase II, beta isozyme; topo II beta; topoisomerase (DNA) II beta 180kDa; topoisomerase II; topoisomerase II beta; topoisomerase IIb; U937 associated antigen; unnamed protein product
基因别名: BILU; D230016L12Rik; Top-2; TOP2B; top2beta; TOPIIB
UniProt ID: (Human) Q02880, (Mouse) Q64511
Entrez Gene ID: (Human) 7155, (Mouse) 21974